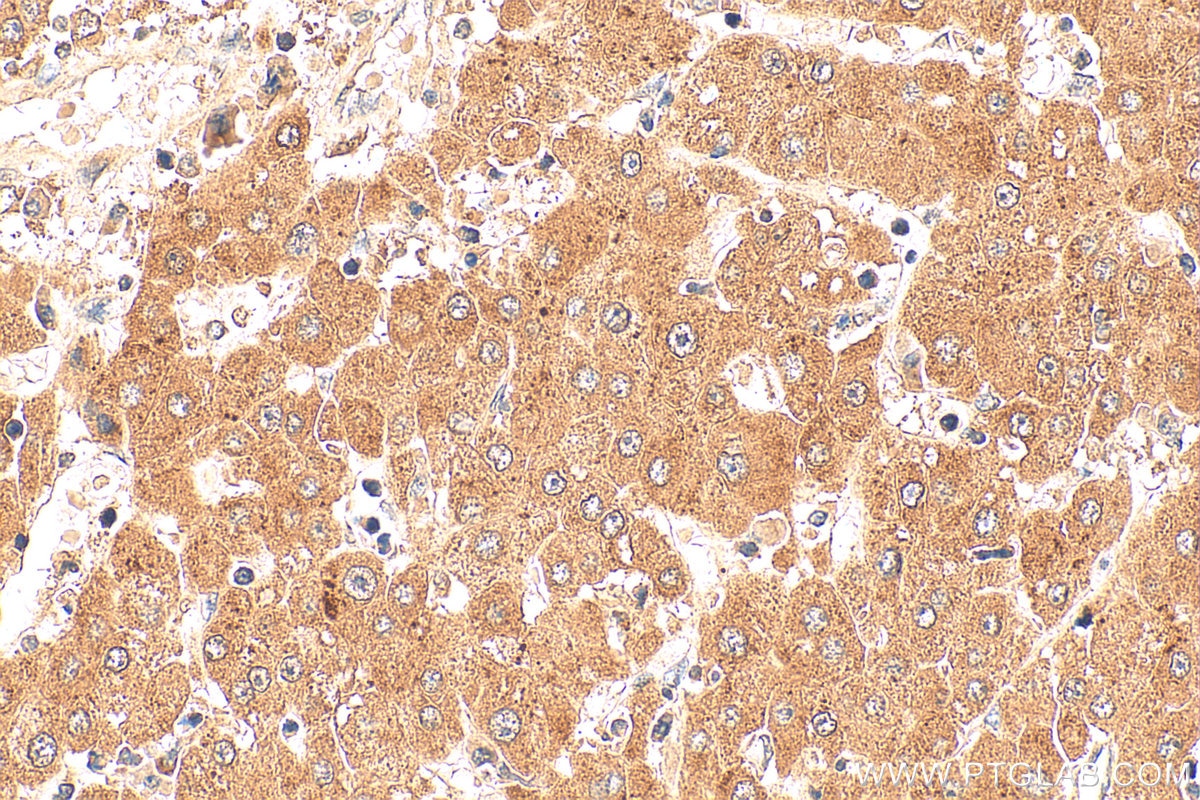
Immunohistochemistry (IHC) staining of human liver cancer tissue using PEX19 Monoclonal antibody (68555-1-Ig)

Tested Applications
| Positive WB detected in | LNCaP cells, HEK-293 cells, HeLa cells, A549 cells, Jurkat cells, K-562 cells, Pig liver tissue, Rat liver tissue, Mouse liver tissue |
| Positive IHC detected in | human liver cancer tissue Note: suggested antigen retrieval with TE buffer pH 9.0; (*) Alternatively, antigen retrieval may be performed with citrate buffer pH 6.0 |
| Positive IF/ICC detected in | Jurkat cells, HeLa cells |
Recommended dilution
| Application | Dilution |
|---|---|
| Western Blot (WB) | WB : 1:5000-1:50000 |
| Immunohistochemistry (IHC) | IHC : 1:200-1:800 |
| Immunofluorescence (IF)/ICC | IF/ICC : 1:200-1:800 |
| It is recommended that this reagent should be titrated in each testing system to obtain optimal results. | |
| Sample-dependent, Check data in validation data gallery. | |
Product Information
68555-1-Ig targets PEX19 in WB, IHC, IF/ICC, ELISA applications and shows reactivity with human, mouse, rat, pig samples.
| Tested Reactivity | human, mouse, rat, pig |
| Host / Isotype | Mouse / IgG1 |
| Class | Monoclonal |
| Type | Antibody |
| Immunogen |
CatNo: Ag6858 Product name: Recombinant human PEX19 protein Source: e coli.-derived, PET28a Tag: 6*His Domain: 1-299 aa of BC000496 Sequence: MAAAEEGCSVGAEADRELEELLESALDDFDKAKPSPAPPSTTTAPDASGPQKRSPGDTAKDALFASQEKFFQELFDSELASQATAEFEKAMKELAEEEPHLVEQFQKLSEAAGRVGSDMTSQQEFTSCLKETLSGLAKNATDLQNSSMSEEELTKAMEGLGMDEGDGEGNILPIMQSIMQNLLSKDVLYPSLKEITEKYPEWLQSHRESLPPEQFEKYQEQHSVMCKICEQFEAETPTDSETTQKARFEMVLDLMQQLQDLGHPPKELAGEMPPGLNFDLDALNLSGPPGASGEQCLIM Predict reactive species |
| Full Name | peroxisomal biogenesis factor 19 |
| Calculated Molecular Weight | 33 kDa |
| Observed Molecular Weight | 35-40 kDa |
| GenBank Accession Number | BC000496 |
| Gene Symbol | PEX19 |
| Gene ID (NCBI) | 5824 |
| RRID | AB_3085258 |
| Conjugate | Unconjugated |
| Form | Liquid |
| Purification Method | Protein G purification |
| UNIPROT ID | P40855 |
| Storage Buffer | PBS with 0.02% sodium azide and 50% glycerol, pH 7.3. |
| Storage Conditions | Store at -20°C. Stable for one year after shipment. Aliquoting is unnecessary for -20oC storage. 20ul sizes contain 0.1% BSA. |
Background Information
Peroxins (PEXs) are proteins that are essential for the assembly of functional peroxisomes. PEX19 gene is necessary for early peroxisomal biogenesis. It acts both as a cytosolic chaperone and as an import receptor for peroxisomal membrane proteins (PMPs) (PMID: 14709540). PEX19 may bind newly synthesized PMPs and facilitate their insertion into the peroxisome membrane (PMID: 107044440. The peroxisome biogenesis disorders (PBDs) are a group of genetically heterogeneous autosomal recessive, lethal diseases characterized by multiple defects in peroxisome function. Defects in this gene are a cause of Zellweger syndrome (ZWS), as well as peroxisome biogenesis disorder complementation group 14 (PBD-CG14) (PMID:20683989) (PMID:10051604).
Protocols
| Product Specific Protocols | |
|---|---|
| IF protocol for PEX19 antibody 68555-1-Ig | Download protocol |
| IHC protocol for PEX19 antibody 68555-1-Ig | Download protocol |
| WB protocol for PEX19 antibody 68555-1-Ig | Download protocol |
| Standard Protocols | |
|---|---|
| Click here to view our Standard Protocols |